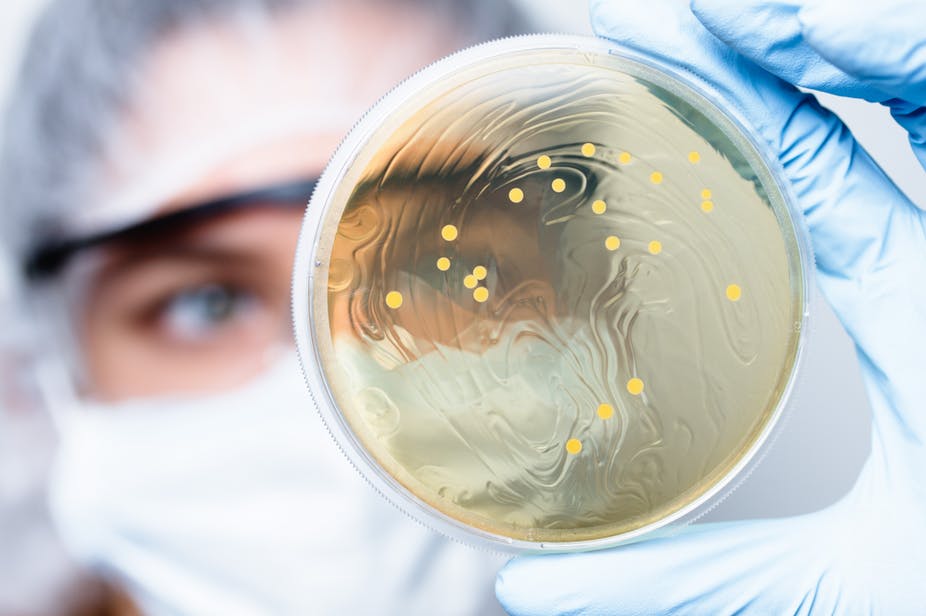
Soigner l’autisme grâce à l’intestin ?

Comme d’autres maladies neurodéveloppementales, l’autisme a une importante origine génétique : les mutations de certains gènes influent sur la sévérité de l’atteinte. Mais le rôle de ces gènes ne se limite pas à notre seul organisme.
Nos travaux révèlent en effet que certains des micro-organismes qui composent la flore intestinale sont sensibles aux mutations de ces gènes impliqués dans l’autisme. Leur abondance diminue lorsque ces derniers sont inactivés. Or on sait aujourd’hui que notre flore intestinale joue un rôle important non seulement dans la digestion, mais aussi dans d’autres fonctions de notre corps, notamment neurologiques.
En restaurant l’équilibre de la flore intestinale de souris modèles pour l'autisme, nous avons réussi à diminuer leurs symptômes. Ces travaux suggèrent que l’on pourra peut-être, demain, envisager de soulager des patients atteints de certains troubles du spectre autistique grâce à des probiotiques.
Découvrez l’histoire étonnante du dialogue étroit qui se met en place entre les bactéries intestinales et leur hôte autiste.
Des gènes impliqués dans la sévérité de l’atteinte
Selon le DSM-5, les troubles du spectre de l’autisme (TSA) recouvrent des catégories de troubles neurodéveloppementaux caractérisés par des déficits persistants de la communication et des interactions sociales, des comportements, intérêts et/ou activités restreints et répétitifs, une hyper ou hypoactivité, avec ou sans déficit intellectuel, avec ou sans altération du langage.
Ces troubles, qui apparaissent en règle générale avant 3 ans, sont empreints de la personnalité de chaque individu et dépendent autant du terrain génétique de la personne que de l’environnement dans lequel celle-ci évolue. Il est estimé qu’aujourd’hui 1 personne sur 68 est concernée par ces TSA. Le ratio généralement constaté est de 1 fille pour 4 garçons diagnostiqués, mais celui-ci semble être sous-estimé concernant les filles.
À lire aussi : Ces femmes autistes qui s’ignorent
Une étude de 2014 a établi une corrélation entre les mutations des gènes de la famille SHANK (SHANK1, SHANK2 et SHANK3, qui sont impliqués dans le développement et le fonctionnement des circuits de neurones), le degré de sévérité de l’atteinte et les caractéristiques physiques des patients. Parmi les mutations affectant les trois gènes SHANK, les patients dont le gène SHANK3 est muté ont un quotient intellectuel plus faible que les deux autres sous-groupes.
Le microbiote, acteur du bon fonctionnement de notre corps
Des études récentes ont montré que certaines maladies neurodéveloppementales pourraient être en lien avec des dérèglements du microbiote. Ce terme désigne l’ensemble des micro-organismes non pathogènes (bactéries, virus, parasites et champignons) que l’on trouve sur la peau, dans la bouche, ainsi qu’au sein des appareils respiratoire, uro-génital et digestif.
Dans notre appareil digestif, le microbiote intestinal, ou « flore intestinale », comporte à lui seul jusqu’à 100 000 milliards de micro-organismes, soit environ 2 kg du poids total du corps. On sait aujourd’hui qu’il joue un rôle important non seulement dans les fonctions digestives et métaboliques, mais aussi immunitaires et neurologiques. L’altération de la composition ou du fonctionnement de la flore intestinale (ou « dysbiose ») est impliquée dans un certain nombre de pathologies allant du cancer aux maladies d’Alzheimer ou de Parkinson, en passant par l’addiction, la dépression, la schizophrénie ou l’autisme.
Ce dialogue entre le microbiote intestinal et le cerveau se fait de façon directe : les micro-organismes produisent des composés agissant à plusieurs niveaux. Certaines de ces molécules sont similaires aux molécules utilisées par les neurones pour communiquer entre eux, d’autres peuvent activer le système immunitaire ou intervenir sur la régulation des hormones.
Les gènes associés aux problèmes neurodéveloppementaux, comme l’autisme, peuvent-ils aussi influencer la flore intestinale ? En retour, cette flore perturbée peut-elle aggraver les pathologies ?
Chez les personnes autistes, une flore intestinale différente
Pour le découvrir, notre équipe a tout d’abord analysé le profil du microbiote intestinal chez les souris portant la mutation Shank3, et l’a comparé à celui de souris « normales » (contrôles). Il s’est agi de déterminer quelles espèces de bactéries vivaient dans l’intestin des deux catégories de souris, dans quelles proportions, etc. La composition de notre microbiote dépend, entre autres choses, de la manière dont nous naissons (par césarienne ou voies naturelles), des lieux où nous vivons, de la façon dont nous nous nourrissons, de nos habitudes de vie… Un peu comme les empreintes digitales, c'est une signature qui nous est propre.
Les résultats que nous avons obtenus montrent que le microbiote des souris porteuses d’un gène muté diffère de celui des souris « normales » à la fois dans la composition et dans la diversité des bactéries qui le constituent : certains phylum, genres et espèces de bactéries sont sur ou sous représentés.
Ainsi, si l’on considère les deux sortes de bactéries majoritaires dans la flore intestinale humaine, les Firmicutes et les Bacteroïdetes, le premier groupe est sous exprimé alors que le second est sur exprimé, avec une diminution plus marquée chez les femelles SHANK3 mutés par rapport aux mâles.
Les genres Prevotella, (bactérie orale, vaginale et intestinale, impliquée dans l’obésité, inflammation de l’intestin et des voies respiratoires…) Christensenella (bactérie intestinale, impliquée dans l’obésité, le cholestérol, le diabète…), Streptococcus (naturellement trouvées dans les mucosités, les cavités orales, les voies respiratoires hautes, les voies digestives), Coprococcus (bactéries du microbiote fécal) mais surtout Lactobacillus (bactéries lactiques vaginales, orales, intestinales présentes dans le lait maternel et utilisées dans la production des produits fermentés) sont sous-exprimés chez les souris mutées.
En revanche, Veillonella (bactéries buccales et intestinales, impliquées dans la formation des caries et dans le syndrome de fatigue chronique…) et Akkermansia (bactéries intestinales, impliquées dans l’obésité, le diabète, l’inflammation de l’intestin…) sont sur exprimées.
Nous nous sommes concentrés sur le genre Lactobacillus, et en particulier sur l’espèce Lactobacillus reuteri (L. reuteri). Cette bactérie lactique probiotique est commercialisée en pharmacie afin de lutter contre les coliques du nourrisson. Elle produit de la reuterine, une molécule antibiotique inhibant la croissance de bactéries potentiellement pathogènes telles que Escherichia coli.
Quand les bactéries intestinales modifient l’activité cérébrale
Des études récentes montrent que L. reuteri produit et sécrète du GABA (ou une molécule très similaire), un composé utilisé dans la communication nerveuse. Celui-ci agit directement au niveau du cerveau en se fixant à d’autres molécules (appelées « récepteurs ») situées sur les cellules.
Rappelons que les souris portant la mutation ShanK3 reproduisent deux des traits les plus prédominants de l’autisme : un comportement répétitif compulsif et un évitement des interactions sociales. Chez ces souris, le nombre de récepteurs de plusieurs molécules, dont le GABA, diffère par rapport à ceux des souris normales. Par exemple, dans l’hippocampe (zone du cerveau impliquée dans la mémoire), les récepteurs GABA sont moins nombreux, alors que dans le cortex préfrontal (région jouant un rôle important dans les émotions et les troubles de l’humeur), on en trouve davantage. Des différences existent également pour d’autres récepteurs comme ceux de l’ocytocine (hormone sécrétée par l’hypophyse) et du glutamate (acide aminé impliqué dans la transmission des messages nerveux).
Nous avons aussi découvert que ces différences sont corrélées avec l’abondance et l’expression des bactéries L. reuteri au niveau de l’intestin. Ces corrélations sont soit négatives, soit positives, mais elles sont significatives. L’analyse, enfin, de six cytokines (hormones du système immunitaire) dans le plasma de nos souris mutées et contrôles nous a permis de constater que les expressions de ces dernières ne sont plus régulées chez les souris mutées et qu’il y avait une corrélation significative entre celles-ci et les bactéries L. reuteri.
Toutes ces observations et ces analyses nous ont permis de conclure qu’il y existe une vraie différence entre les souris porteuses de la mutation Shank3 et les souris contrôles, non seulement au niveau cérébral, mais aussi au niveau du système immunitaire.
Ces différences étant corrélées avec des différences au niveau de la composition en bactéries L. reuteri dans l’intestin, nous avons eu l’idée de pousser plus loin nos investigations.
L. reuteri à la rescousse
Vendu en tant que probiotique, L. reuteri a été décrite dans des études récentes comme jouant un rôle dans le comportement social et le stress. Nous avons donc décidé de donner cette bactérie, cultivée par nos soins, en gavage à des souris mutées âgées de quatre semaines. Deux groupes ont été ainsi mis en place : un groupe contrôle, constitué des souris mutées n’ayant pas reçu la bactérie, et un groupe constitué des souris mutées ayant reçu la bactérie. Des tests de comportements sociaux ont été effectués après ce régime à base de L. reuteri, puis nous avons sacrifié les souris pour étudier à nouveau leurs différents récepteurs et hormones.
L’autisme est une pathologie humaine, et tous les traits autistiques ne sont pas étudiés dans cette étude qui recourt à des modèles animaux. Toutefois, les résultats des analyses comportementales que nous avons menées sont intéressants. Tout d’abord, mâles et femelles n’ont pas répondu de la même manière à l’apport de L. reuteri. Les premiers ont vu leurs déficits sociaux et leurs comportements répétitifs s’atténuer. Chez les mâles, L. reuteri stimule l’intérêt pour les souris qu’elles ne connaissent pas. En revanche, leurs comportements anxieux ne sont que très peu affectés.
Les femelles ont réagi différemment à la bactérie L. reuteri. Elles se sont montrées moins attirées par les nouvelles interactions sociales. En outre, leurs comportements répétitifs ont significativement diminué, tout comme leur anxiété, bien que de manière non significative. Des analyses moléculaires ont montré que le gavage avec L. reuteri a eu un effet direct sur les différentes régions cérébrales et la composition en cytokines dans le plasma des souris.
Ces résultats laissent supposer que le microbiote intestinal pourrait avoir joué un rôle durant le développement du cerveau. Étant donné que le gène Shank3 est aussi exprimé dans les neurones de l’intestin, il pourrait être impliqué dans l’altération et la modification du microbiote. Ce qui expliquerait les différences entre la flore intestinale des personnes souffrant de troubles du spectre autistique en raison d’un gène SHANK3 muté et celle des personnes non affectées.
Continuer à décrypter les interactions avec notre microbiote
Cette étude donne un premier aperçu des liens qui existent entre le profil génétique de l’hôte et sa flore intestinale. Il faudra désormais enquêter plus avant sur la façon dont le génome des personnes autistes interagit avec leur microbiote intestinal et le modifie.
Par ailleurs, ces résultats ouvrent une nouvelle piste à explorer dans le traitement de l’autisme : celle des probiotiques. Malgré leur passage temporaire dans l’intestin, ils sont actifs, et les prendre n’est pas sans conséquence.
Le dialogue entre le génome des personnes autistes et leur microbiote est de plus en plus audible. Reste maintenant à le comprendre.
![]()